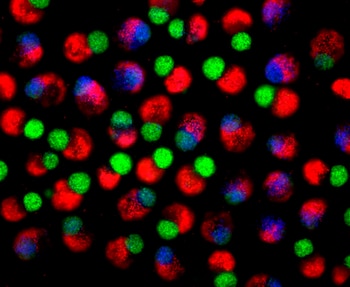
La plataforma utiliza un andamiaje

Imagen de microscopía electrónica de barrido del tejido de médula ósea tridimensional diseñado y colonizado con células sanguíneas humanas (rojo). Crédito: Andrés García García, Departamento de Biomedicina, Universidad de Basilea.
Imagen de microscopía electrónica de barrido del tejido de médula ósea tridimensional diseñado y colonizado con células sanguíneas humanas (rojo). Crédito: Andrés García García, Departamento de Biomedicina, Universidad de Basilea.
Un equipo de investigadores en Suiza desarrolló por primera vez una médula ósea humana en miniatura capaz de producir sangre de manera sostenida. El experimento, realizado en la Universidad de Basilea, alcanzó un hito al reproducir la estructura funcional de la médula ósea dentro de un modelo tridimensional.
Luego de varios ensayos, los investigadores lograron que la plataforma replicara fielmente la variedad celular y las señales moleculares presentes en la médula ósea real.
Este avance se realizó en el Departamento de Biomedicina de la Universidad de Basilea y en el Hospital Universitario de Basilea, donde científicos recurrieron exclusivamente a células humanas.
 Científicos suizos desarrollan la primera médula ósea humana en miniatura capaz de producir sangre durante semanas en laboratorio (Imagen Ilustrativa Infobae)
Científicos suizos desarrollan la primera médula ósea humana en miniatura capaz de producir sangre durante semanas en laboratorio (Imagen Ilustrativa Infobae)
El modelo demostró capacidad de generar células sanguíneas durante varias semanas, ofreciendo una estructura funcional idéntica a la de los huesos humanos. Los expertos anticiparon que la nueva tecnología permitirá estudiar enfermedades de la sangre y evaluar fármacos con mayor precisión, todo en un entorno controlado.
El equipo científico construyó un andamiaje de hidroxiapatita, mineral natural de huesos y dientes humanos, donde incorporó células humanas pluripotentes.
De acuerdo con Science Daily, estas células, reprogramadas en el laboratorio, evolucionaron en distintas líneas celulares de la médula ósea al recibir las señales moleculares apropiadas.
 Imagen generada por computadora que muestra un virus rodeado por células del sistema inmunológico. La ilustración destaca la interacción entre el patógeno y las defensas del cuerpo humano, un tema central en la investigación biomédica actual. (Imagen Ilustrativa Infobae)
Imagen generada por computadora que muestra un virus rodeado por células del sistema inmunológico. La ilustración destaca la interacción entre el patógeno y las defensas del cuerpo humano, un tema central en la investigación biomédica actual. (Imagen Ilustrativa Infobae)
Según la Universidad de Basilea, el nuevo sistema reproduce con exactitud el nicho endosteal, un microambiente especializado de la médula ósea clave en la formación de células sanguíneas.
Este nicho, situado cerca de la superficie ósea, incluye vasos sanguíneos, células inmunitarias, terminaciones nerviosas y células óseas. Antes de este trabajo, ningún modelo íntegramente humano había conseguido integrar todos estos elementos de manera simultánea y funcional.
Los modelos tradicionales empleaban principalmente células de ratón o estructuras simplificadas, lo que impedía estudiar la complejidad total de los procesos humanos.
“Hemos aprendido mucho de los ratones, pero este modelo nos aproxima a la biología real del ser humano”, afirmó Ivan Martin, líder del equipo de investigación.
La plataforma utiliza un andamiaje de hidroxiapatita y células humanas pluripotentes para recrear el microambiente óseo y sanguíneo (Créditos: Jitesh Neupane, University of Cambridge)
La plataforma utiliza un andamiaje de hidroxiapatita y células humanas pluripotentes para recrear el microambiente óseo y sanguíneo (Créditos: Jitesh Neupane, University of Cambridge)
El modelo tridimensional mide ocho milímetros de diámetro por cuatro milímetros de espesor. Estos parámetros lo convierten en uno de los sistemas más grandes y completos desarrollados hasta la fecha.
La plataforma permitió mantener la producción de células sanguíneas por varias semanas. Los investigadores comprobaron que la diversidad y el ritmo de generación celular coincidían con los parámetros fisiológicos propios del organismo humano.
De acuerdo con el estudio, el sistema podrá utilizarse, en una primera etapa, para analizar cómo se originan y desarrollan los cánceres de sangre. Además, facilitará el testeo de medicamentos en condiciones más parecidas a las humanas.
 El avance abre la puerta a reducir el uso de animales en ensayos biomédicos y promueve alternativas más éticas y precisas en investigación (Imagen Ilustrativa Infobae)
El avance abre la puerta a reducir el uso de animales en ensayos biomédicos y promueve alternativas más éticas y precisas en investigación (Imagen Ilustrativa Infobae)
El desarrollo de este modelo responde a la necesidad de contar con alternativas más precisas y éticas para la investigación biomédica.
De acuerdo con Ivan Martin, esta plataforma se alinea con los esfuerzos globales para reducir, refinar y eventualmente reemplazar los experimentos realizados con animales en laboratorios. El modelo artificial reproduce la complejidad de los huesos humanos y su microambiente, lo que abre la puerta a nuevos protocolos experimentales.
Andrés García García, coautor del estudio, explicó que el tamaño del nuevo modelo podría representar un desafío para experimentos que requieran analizar grandes cantidades de fármacos al mismo tiempo.
Para tales fines, la plataforma necesitará ser adaptada. Sin embargo, el avance ya permite evaluar tratamientos, analizar la resistencia de células cancerígenas o investigar la eficacia y seguridad de moléculas en desarrollo.
 El avance abre la puerta a reducir el uso de animales en ensayos biomédicos y promueve alternativas más éticas y precisas en investigación (Imagen Ilustrativa Infobae)
El avance abre la puerta a reducir el uso de animales en ensayos biomédicos y promueve alternativas más éticas y precisas en investigación (Imagen Ilustrativa Infobae)
En investigaciones futuras, los científicos prevén construir modelos personalizados de médula ósea tomando como base células del propio paciente. Así, los profesionales médicos podrían identificar las terapias más eficaces para cada individuo antes de iniciar tratamientos.
Esta estrategia representaría un paso adelante hacia la medicina personalizada y podría mejorar la tasa de éxito en el tratamiento de enfermedades hematológicas.
La tecnología desarrollada por el equipo suizo demuestra que es posible reproducir la formación sanguínea humana fuera del cuerpo, lo que representa un avance relevante para la medicina moderna.
La plataforma ya ofrece una alternativa concreta para estudiar leucemias y otros tipos de cáncer de la sangre, además de servir para la prueba de medicamentos de manera más segura y efectiva.
Los científicos reconocen que el perfeccionamiento de este modelo requerirá investigaciones adicionales. De acuerdo con la Universidad de Basilea, estas mejoras permitirán ampliar la funcionalidad de la plataforma y convertirla, en el futuro, en una herramienta central para la medicina personalizada. El trabajo ha sido publicado en la revista Cell Stem Cell durante noviembre de 2025.
